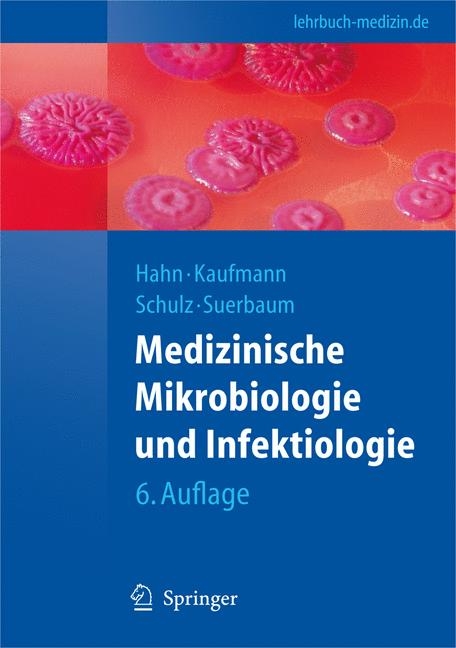
Medizinische Mikrobiologie und Infektiologie -

Medizinische Mikrobiologie und Infektiologie (eBook)
XXIV, 890 Seiten
Springer Berlin (Verlag)
978-3-540-46362-7 (ISBN)
Herr Professor Sebastian Suerbaum lehrt in Hannover an der MHH Mikrobiologie für Mediziner. Herr Professor Thomas Schulz ist ebenfalls in Hannover und lehrt an der MHH den Virologie-Part für Mediziner. Herr Professor Stefan H.E. Kaufmann ist geschäftsführender Direktor des Max-Planck-Instituts für Infektionsbiologie in Berlin. Herr Professor Helmut Hahn ist emeritiert und im Vorstand der Berliner Medizinischen Gesellschaft aktiv.
Grundlagen.- Die Medizinische Mikrobiologie im 21. Jahrhundert.- Ursprung der Medizinischen Mikrobiologie.- Pathogenität und Virulenz.- Infektion.- Physiologische Bakterienflora: Kolonisationsresistenz, endogene Opportunisteninfektionen; Probiotika.- Immunologie.- Grundbegriffe.- Zellen des Immunsystems.- Organe des Immunsystems.- Antikörper und ihre Antigene.- Komplement.- Antigen-Antikörper-Reaktion: Grundlagen serologischer Methoden.- Haupt- Histokompatibilitäts- Komplex.- T-Zellen.- Mononukleäre Phagozyten und antigenpräsentierende Zellen.- Immunpathologie.- Infektabwehr.- Diagnostik.- Klinische Diagnostik.- Gewinnung und Handhabung von Materialien zur mikrobiologischen Diagnostik.- Methoden der mikrobiologischen Diagnostik.- Epidemiologie und Prävention.- Epidemiologie der Infektionskrankheiten.- Prävention von Bakterien- und Virusinfektionen.- Sterilisation und Desinfektion.- Bakteriologie.- Bakterien: Definition und Aufbau.- Bakterien: Vermehrung und Stoffwechsel.- Staphylokokken.- Streptokokken.- Enterokokken und weitere katalasenegative gram-positive Kokken.- Neisserien.- Enterobakterien.- Vibrionen, Aeromonas.- Nichtfermentierende Bakterien (Nonfermenter): Pseudomonas, Burkholderia, Stenotrophomonas, Acinetobacter.- Campylobacter.- Helicobacter.- Haemophilus.- Bordetellen.- Legionellen.- Anthropozoonoseerreger ohne Familienzugehörigkeit: Listerien, Brucellen, Francisellen und Erysipelothrix.- Korynebakterien.- Bacillus.- Obligat anaerobe sporenbildende Ståbchen (Clostridien).- Nichtsporenbildende obligat anaerobe Bakterien.- Mykobakterien.- Nocardien und aerobe Aktinomyzeten.- Treponemen.- Borrelien.- Leptospiren.- Rickettsiaceae (Rickettsia, Orientia), Anaplasmataceae (Anaplasma, Ehrlichia, Neorickettsia) und Coxiellaceae.- Bartonellen.- Mykoplasmen und Ureaplasmen.- Chlamydien.- Weitere medizinisch bedeutsame Bakterien.- Virologie.- Virusbegriff — Struktur — Einteilung.- Virusreplikation.- Pathogenität — Infektionsverlauf.- Virus und Tumor: wie können Viren maligne Erkrankungen auslösen?.- Picorna-Viren.- Flavi-Viren.- Röteln-Virus.- Corona-Viren.- Orthomyxo-Viren: Influenza.- Paramyxo-Viren.- Tollwut-Virus.- Arena-Viren.- Bunya-Viren.- Filo-Viren.- Virus-Gastroenteritis.- Humane Immundefizienz-Viren (HIV-1, HIV-2).- Humane T-lymphotrope Viren (HTLV-1, HTLV-2).- Parvo-Viren.- Papillom- und Polyoma-Viren.- Adeno-Viren.- Herpes-Viren.- Virushepatitis.- Pocken-Viren.- Prion-Krankheiten.- Mykologie.- Pilze:Vorkommen und Bedeutung für den Menschen.- Biologie der Pilze.- Hefen.- Filamentös wachsende Pilze (Fadenpilze).- Dermatophyten.- Dimorphe Pilze.- Parasitologie.- Allgemeine Parasitologie.- Protozoen.- Trematoden.- Cestoden.- Nematoden.- Ektoparasiten.- Antimikrobielle und antivirale Chemotherapie.- Allgemeines.- Antibakterielle Wirkung.- Resistenz.- Pharmakokinetik.- Applikation und Dosierung.- Nebenwirkungen.- Auswahl von antimikrobiellen Substanzen (Indikation).- Antibiotika.- Cephalosporine.- ?-Laktamase-Inhibitoren.- Carbapeneme.- Glykopeptidantibiotika.- Aminoglykoside.- Tetracycline (Doxycyclin).- Lincosamine (Clindamycin).- Makrolide.- Antimikrobielle Folsäureantagonisten.- Fluorchinolone.- Antimykobakterielle Therapeutika.- Weitere antibakterielle Substanzen.- Antimykotika.- Virus-Chemotherapie.- Antiparasitäre Substanzen.- Krankheitsbilder.- zu den klinisch-infektiologischen Kapiteln.- Sepsis.- Mikrobielle (bakterielle) Endokarditis.- Bakterielle Meningitis.- Akute und chronische Virus-Erkrankungen des Zentralnervensystems.- Augeninfektionen.- Infektionen des oberen Respirationstrakts.- Pneumonie.- Harnwegsinfektionen.- Genitaltraktinfektionen und sexuell übertragbare Krankheiten.- Gastroenteritiden.- Mikrobiell bedingte Arthritis.- Osteomyelitis.- Haut- und Weichgewebsinfektionen.- Intraabdominelle Infektionen.- Nosokomiale Infektionen.- Infektionen bei geriatrischen Patienten.- Importierte Infektionen.- Biologische Waffen — eine Herausforderung an Diagnostik, Therapie, Klinik und Prävention.
| Erscheint lt. Verlag | 24.3.2009 |
|---|---|
| Reihe/Serie | Springer-Lehrbuch |
| Illustrationen | Klaus Adler, Diane Schad, Timo Ulrichs |
| Verlagsort | Berlin |
| Sprache | deutsch |
| Themenwelt | Medizin / Pharmazie |
| Schlagworte | Antibiotika • Antibiotikatherapie • antimikrobielle Chemotherapie • Bakterien • Bakteriologie • Hygiene • Immunologie • Infektiologie • Mykologie • Parasitologie • Virologie |
| ISBN-10 | 3-540-46362-3 / 3540463623 |
| ISBN-13 | 978-3-540-46362-7 / 9783540463627 |
| Informationen gemäß Produktsicherheitsverordnung (GPSR) | |
| Haben Sie eine Frage zum Produkt? |
Kopierschutz: Adobe-DRM
Adobe-DRM ist ein Kopierschutz, der das eBook vor Mißbrauch schützen soll. Dabei wird das eBook bereits beim Download auf Ihre persönliche Adobe-ID autorisiert. Lesen können Sie das eBook dann nur auf den Geräten, welche ebenfalls auf Ihre Adobe-ID registriert sind.
Details zum Adobe-DRM
Dateiformat: PDF (Portable Document Format)
Mit einem festen Seitenlayout eignet sich die PDF besonders für Fachbücher mit Spalten, Tabellen und Abbildungen. Eine PDF kann auf fast allen Geräten angezeigt werden, ist aber für kleine Displays (Smartphone, eReader) nur eingeschränkt geeignet.
Systemvoraussetzungen:
PC/Mac: Mit einem PC oder Mac können Sie dieses eBook lesen. Sie benötigen eine
eReader: Dieses eBook kann mit (fast) allen eBook-Readern gelesen werden. Mit dem amazon-Kindle ist es aber nicht kompatibel.
Smartphone/Tablet: Egal ob Apple oder Android, dieses eBook können Sie lesen. Sie benötigen eine
Geräteliste und zusätzliche Hinweise
Buying eBooks from abroad
For tax law reasons we can sell eBooks just within Germany and Switzerland. Regrettably we cannot fulfill eBook-orders from other countries.
aus dem Bereich